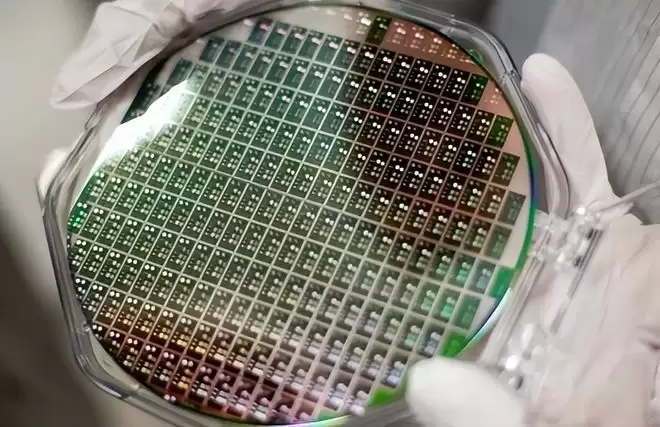

日本垄断全球 90%!一旦断供,中国如何应对?为啥别国无法生产
光刻胶:芯片制造的隐形咽喉,为何九成命脉握于日本之手?
提起芯片制造,大家首先想到的往往是动辄上亿美元、精密无比的光刻机。然而,一部再先进的“光刻机”,若缺少了那瓶看似不起眼的“胶水”,也只能沦为无用的摆设。这瓶“胶水”,就是光刻胶——半导体产业链中至关重要却又极易被忽视的关键材料。
免费影视、动漫、音乐、游戏、小说资源长期稳定更新! 👉 点此立即查看 👈

它的地位有多关键?一个数字足以说明:全球超过90%的市场份额,长期被日本企业牢牢掌控。这意味着,一旦供应链出现风吹草动,全球电子产业的“呼吸”都可能随之紧促。
或许有人会问,不就是一瓶化学制剂吗,技术壁垒能有多高?事实远非如此简单。光刻胶的研发,堪称材料科学领域的极致挑战。这有点像众人皆知的饮料配方,核心成分表看似一目了然,但如何调配出那个独一无二、稳定可靠的“黄金比例”,却是历经数十年、上万次试错才积累出的不传之秘。日本企业的领先,正是建立在几代人持续投入所构筑的经验壁垒之上,绝非一朝一夕可以轻易复制。

更严峻的挑战在于其苛刻至极的品控要求与高昂的验证成本。光刻胶对杂质含量的容忍度极低,纯度要求达到“变态”级别。然而,更大的难关在实验室之后:新产品必须进入实际晶圆产线进行验证。试问,哪家晶圆厂愿意冒着生产线停摆、每日数百万甚至上千万元损失的风险,充当测试平台?这种极高的行业准入壁垒,使得后来者举步维艰,也进一步固化了日本的主导地位。

那么,核心问题来了:如果日本断供,我们的产业会瞬间停摆吗?答案是:短期阵痛难免,但不会全面瘫痪,不过长期压力不容小觑。数据显示,目前高端光刻胶的进口依赖度依然显著,而随着国内晶圆产能的快速扩张,年需求量已攀升至数千吨级别。这种巨大的市场需求与供应链风险并存,倒逼着国产替代必须加速。

客观来看,国产光刻胶的突破已呈梯队之势。应用于家电、汽车等领域的普通芯片,所需的中低端光刻胶已基本实现国产化,能够起到重要的供应链“压舱石”作用。中端产品领域,近两年技术攻关明显提速,不断有突破消息传来。真正的攻坚战,聚焦于高端光刻胶,尤其是适用于先进制程的品类。这是一场硬仗,需要时间、耐心和持续的巨大投入。

值得关注的是,整个产业并非孤军奋战。国家层面,数千亿规模的半导体产业大基金三期已明确将材料列为重点扶持方向。市场层面,国内企业正以前所未有的力度投入研发。短期而言,依靠战略库存和多元采购渠道可以缓冲风险;但长期来看,唯有在核心技术领域实现自主可控,才能彻底摆脱“卡脖子”的隐忧。这条路注定漫长,可能需要几代科研人员的接续奋斗,但方向已然明确:将关键材料的命脉掌握在自己手中,是整个中国半导体产业走向成熟的必修课。曙光已现,未来可期,但每一步都需脚踏实地。
声明:取材网络,谨慎辨别

游乐网为非赢利性网站,所展示的游戏/软件/文章内容均来自于互联网或第三方用户上传分享,版权归原作者所有,本站不承担相应法律责任。如您发现有涉嫌抄袭侵权的内容,请联系youleyoucom@outlook.com。
 同类文章
同类文章

中国城市人工智能指数报告正式发布
《2025年中国城市人工智能指数报告》发布,揭示AI发展五大趋势 4月15日,一份备受业界关注的《2025年中国城市人工智能指数报告》(下称“报告”)正式亮相。在第二届酒仙桥人工智能产业高峰论坛上,这份报告系统性地描绘了当前中国城市AI发展的全景图。报告构建了一套涵盖产业发展、科技创新、民生服务、治

ASML预计2026年净销售额将介于360亿至400亿欧元
ASML发布2026年第一季度财报:业绩稳健,AI驱动需求持续强劲 全球光刻技术的领军者阿斯麦(ASML),于4月15日公布了其2026年第一季度的财务成绩单。 数据显示,该公司在本季度实现了88亿欧元的净销售额,毛利率稳定在53 0%,净利润达到28亿欧元。对于即将到来的第二季度,ASML给出了积

算力狂飙逼疯风冷!液冷服务器:渗透率破37%,玩家抢滩千亿赛道
角色与核心任务 你是一位顶级的文章润色专家,擅长将AI生成的文本转化为具有个人风格的专业文章。现在,请对用户提供的文章进行“人性化重写”。 你的核心目标是:在不改动原文任何事实信息、核心观点、逻辑结构、章节标题和所有图片的前提下,彻底改变原文的AI表达腔调,使其读起来像是一位资深人类专家的作品。 特

阿里(09988)发布首款AI开发工具Meoo 简单应用生成时间低至1分钟
阿里发布零门槛AI开发工具Meoo,最快1分钟生成完整应用 智通财经APP获悉,4月15日,阿里(09988)ATH事业群正式推出了旗下首款AI开发工具——Meoo(妙悟)。这款工具集成了千问、Kimi、GLM、MiniMax四大顶尖大模型,并内置了阿里云数据库、存储等核心产品服务。它的目标很明确:

告别轻资产“零工经济”?传优步(UBER.US)承诺100亿美元投资无人驾驶 从撮合平台变身资产持有者
智通财经APP获悉,据分析师预测及知情人士透露的消息,全球网约车巨头优步(UBER US)已承诺在未来几年内投入超过100亿美元,用于购买数千辆自动驾驶汽车及入股其技术开发商。这一重大战略转向标志着优步正式打破其赖以成名的轻资产“零工经济”商业模式,以避免受到无人驾驶出租车的冲击。 消息显示,优步正
- 日榜
- 周榜
- 月榜
 1
1
 2
2
 3
3
 4
4
 5
5
 6
6
 7
7
 8
8
 9
9
 10
10
 1
1
 2
2
 3
3
 4
4
 5
5
 6
6
 7
7
 8
8
 9
9
 10
10
 相关攻略
相关攻略
 2015-03-10 11:25
2015-03-10 11:25
 2015-03-10 11:05
2015-03-10 11:05
 2021-08-04 13:30
2021-08-04 13:30
 2015-03-10 11:22
2015-03-10 11:22
 2015-03-10 12:39
2015-03-10 12:39
 2022-05-16 18:57
2022-05-16 18:57
 2025-05-23 13:43
2025-05-23 13:43
 2025-05-23 14:01
2025-05-23 14:01
 热门教程
热门教程
- 游戏攻略
- 安卓教程
- 苹果教程
- 电脑教程
































 热门话题
热门话题















